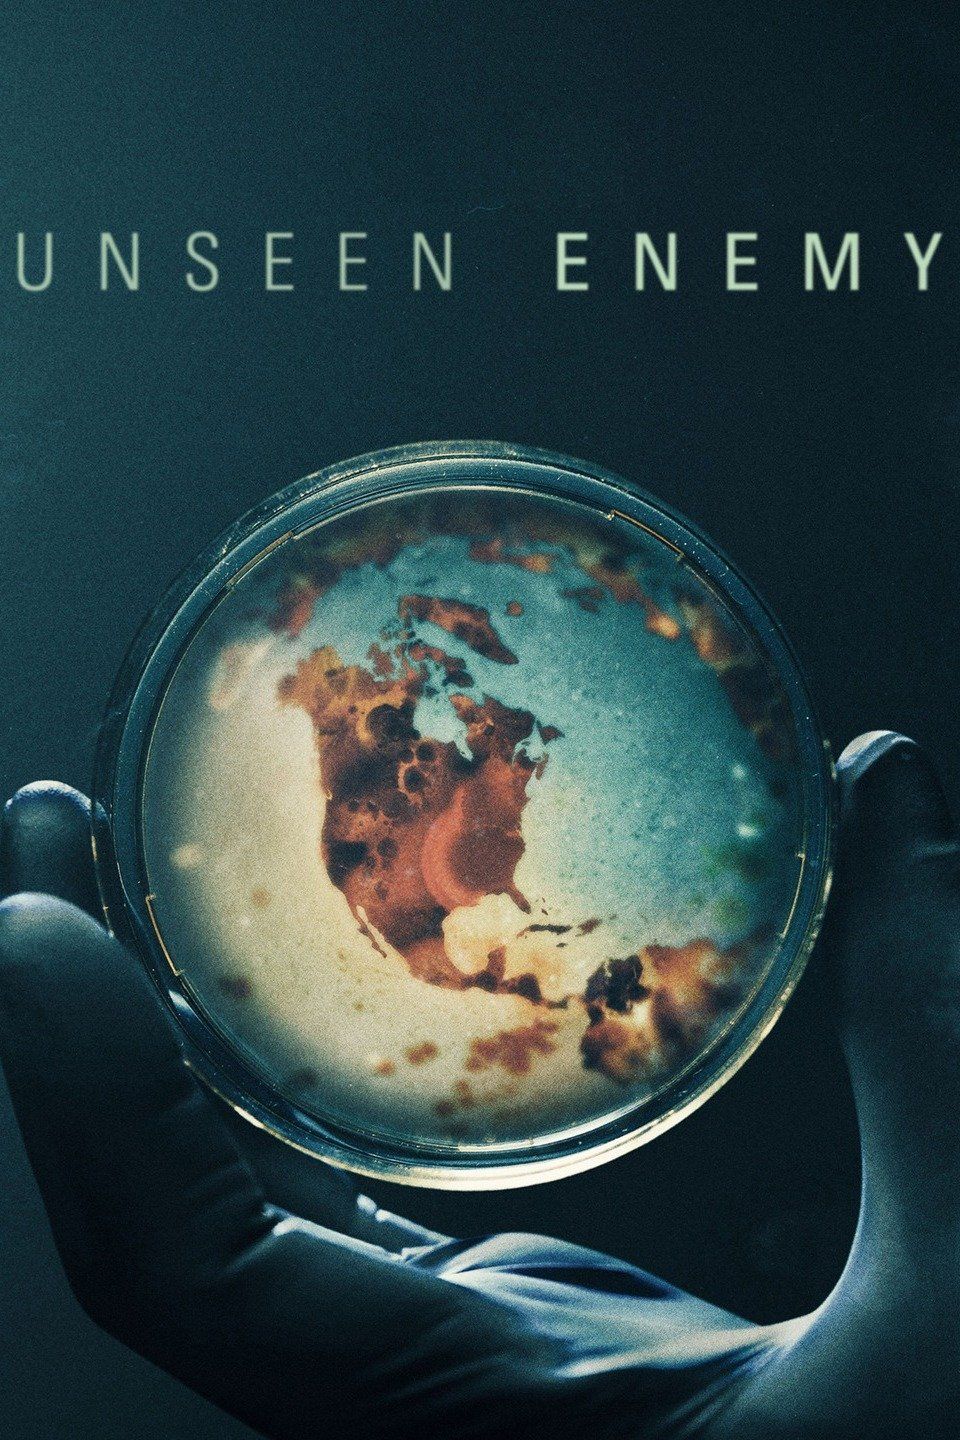

JT

Janet Tobias
Producer, Director, Writer, Additional CreditsBorn January 10, 1958 (67 years)
Janet Tobias Filmography
| 2021 | |
| 2021 | Race for the Vaccine · as Executive Producer |
| 2019 | Unmasked: We All Breathe · as Executive Producer |
| 2018 | |
| 2017 | |
| 2012 | |
| 1983 | Frontline (TV Series) |
| 1974 | NOVA (TV Series) · as Executive Producer |
| 2021 | |
| 2018 | |
| 2017 | |
| 2012 | |
| 1983 | Frontline (TV Series) |
| 2019 | |
| 2018 | |
| 2017 | |
| 1983 | Frontline (TV Series) |
| 2002 | Frontline World (TV Series) · as Self - Reporter |
| 2012 | No Place on Earth · as Written By |